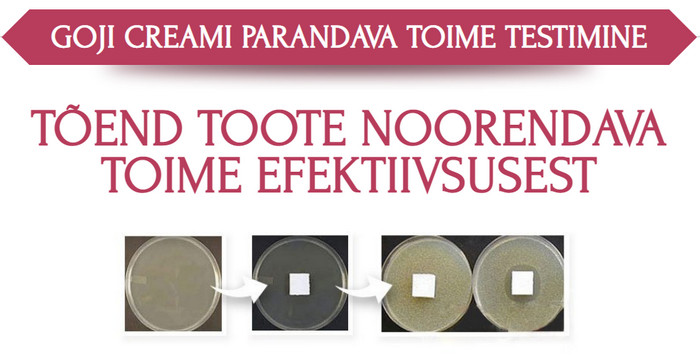

![]()
Goji cream tellimine, foorum, kommentaare, kus osta






Goji cream kasutusjuhend, tulemused, mis on





![]()
Goji cream kasutamine, Eestis, arvamused, hind







Goji cream Eesti, apteegis, kõrvaltoimed, müük

![]()








![]()
Vanusega seotud nahamuutuste vastu võitlemiseks kasutavad paljud tüdrukud ja naised “ilusüste”. Selline protseduur pole aga mitte ainult valus, kulukas, vaid kätkeb endas ka teatud ohtu tervisele. Uuenduslik arendus kosmetoloogia valdkonnas – seerum Goji cream, mille ülevaated on kohe Internetis laiali, võimaldavad teil kiiresti ja ohutult taastada näo esialgse värskuse. Ravim toimib korraga mitmes suunas, mis seletab selle kõrget efektiivsust. Botoxi efektiga seerumit Goji cream on soovitatav osta ametlikult veebisaidilt, et vältida võltsingu omandamist.
Artiklist saate teada, mis on Goji cream, kuidas toode töötab, milleks see on mõeldud, kuidas kasutada Goji cream vastavalt kasutusjuhendile, kus osta Goji cream ja milline on selle hind müük Eestis. Lugege ka tulemused, kommentaare ja arvamused Goji cream kohta on foorum.
Mis on juhtunud Goji cream
Goji cream valmistatud looduslike taimsete koostisosade baasil niisutavad nahka ja suurendavad selle elastsust. Saate edukalt ja kiiresti toime tulla vanusega seotud muutustega epidermis kodus ilma salongi külastamata.
Botoxi efektiga seerumis Goji cream kasutatav peptiidide kompleks aitab kaasa:
- Kalogeeni tootmine
- Muudab naha elastseks
- Kiirendab rakkude taastumist
- Parandab vereringet
- Takistab vanuselaikude teket
Sellel on positiivne mõju naise meeleolule, see aitab leevendada stressi ja pikendada noorust. Niisutav looduslik kreem Goji cream on väga populaarne mitte ainult Venemaal, vaid ka kaugel väljaspool selle piire.
Miks tekivad kortsud?
Vananedes muutub nahk vähem elastseks ja kaotab oma taastumisvõime. Silmaümbruse peen võrk muutub peagi sügavateks kortsudeks, kui me ei aita nahal taastuda. Seerumi pealekandmise protsessis Goji cream Botox efekt peatab uute kortsude tekke ja vähendab vanade kortsude sügavust.
Kortsude teket põhjustavad tegurid:
- Matkida tegevust
- Halvad harjumused
- Alatoitumus
- Välistegurid
- Ebakvaliteetne kosmeetika
- Pärilik eelsoodumus
- Vanuselised protsessid
Meetodid vanusega seotud naha vananemise vastu võitlemiseks
Õnneks pole väide, et aeg on vääramatu, enam nii kategooriline. Kui iga minut loeb, ei tohiks unustada oma välimust. Noorendamise meetodi valimisel tuleb riske õigesti hinnata. Seerum Goji cream Botoxi efektiga, ohutum kui:
- Botoxi subkutaansed süstid
- Mesoteraapia
- Niidi tõstmine
- Kontuurplast
- Ja veelgi enam kirurgiline näo tõstmine
Goji cream – ohutu ja tõhus
Peptiidid pinguldavad ja siluvad nahka, kõrvaldades kortse. Mikroelemendid käivitavad naharakkude taastumisprotsessi. Epidermise struktuuri taastamine toimub erinevalt Botoxi süstidest ilma komplikatsioonide ja ebamugavusteta.
Mõju tulemus kasutamine Goji cream:
- Sügavad kortsud tasandatakse
- Algab rakkude regenereerimise protsess
- Nahk muutub taas pinguldatuks ja elastseks
- Kaovad vanuselaigud
- Kortsude sügavus väheneb 70%
- Rakkude taastumine kiireneb
- Tulemus on nähtav pärast 2-3 protseduuri
Eelised Goji cream:
- Looduslikud koostisosad
- Allergiliste reaktsioonide puudumine
- Kiire tulemus
- Naha täisväärtuslik toitumine
- Takistab uute kortsude teket
Niisutaja eelised
Ravim koosneb 100% looduslikest koostisosadest, mille toime on suunatud närbumisprotsesside vastu võitlemisele. Goji cream ei oma kõrvaltoimed!
Näokreem Goji cream loodusliku pärlipuudriga niisutav koostis sisaldab:
- On võimsate vananemisvastaste omadustega, annab nahale endise värskuse ja nooruse
- Aitab taastada veetasakaalu, taastab kapillaaride painduvuse ja tugevuse, peatab enneaegsed vananemisprotsessid
- Taastab rasunäärmete normaalse talitluse, puhastab ummistunud poorid, kõrvaldab punetuse, põletiku, akne
- On tugevate antiseptiliste ja põletikuvastaste omadustega. Võitleb edukalt bakterite ja patogeensete mikroobidega
- Epidermise nooruse, ilu ja tervise allikas
Kreemiga võite julgelt unustada kallid protseduurid ja operatsioonid.
Peamised eelised on järgmised:
- Kõrvaldab väsimuse ja unetuse märgid, tumedad silmaalused
- Kõrvaldab punetuse, pigmentatsiooni
- Silub sügavaid kortse
- Annab nahale elastsuse, sileduse, tiheduse, elastsuse, kauni mati värvi
- Pinguldab ja korrigeerib näoovaali
- Kõrvaldab “brylya”, “kotid” silmade all ja struktuuri rabeduse
- Aktiveerib kudede regenereerimise protsessi rakutasandil
Pärlitega kreem peatab närbumise, taastab nahale nooruslikkuse ja täiusliku välimuse! See seerum ei täida kortse ja silub koheselt peeneid kortse. See põhineb uuenduslikul kombinatsioonil looduslikest antioksüdantidest ja vananemisvastastest koostisosadest, vitamiinidest A ja C, mis kaitsevad nahka ja soodustavad uue kollageeni tootmist. Seerum parandab naha elastsust ja soodustab tervete rakkude kasvu. Goji cream apteegis tellimine ei saa.
-50%
![]()